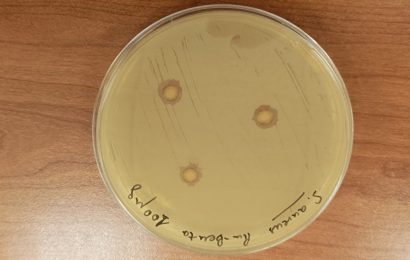

Andalucía Emprende, fundación adscrita a la Consejería de Universidad, Investigación e Innovación, y MicroBank han suscrito un convenio para colaborar en la décimo tercera edición de los ‘Premios Emprendemos’, destinados a reconocer a las ‘startups’ andaluzas más innovadoras y con mayor impacto social del ecosistema emprendedor. El acuerdo permitirá otorgar…